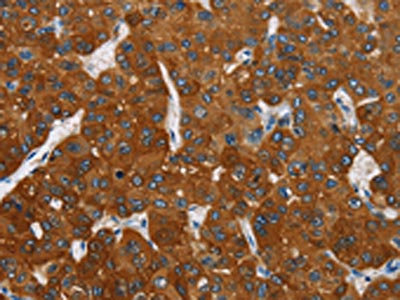

CARD9 Antibody
-
中文名稱:CARD9兔多克隆抗體
-
貨號:CSB-PA233585
-
規格:¥1100
-
圖片:
-
The image on the left is immunohistochemistry of paraffin-embedded Human liver cancer tissue using CSB-PA233585(CARD9 Antibody) at dilution 1/70, on the right is treated with fusion protein. (Original magnification: ×200)
-
The image on the left is immunohistochemistry of paraffin-embedded Human thyroid cancer tissue using CSB-PA233585(CARD9 Antibody) at dilution 1/70, on the right is treated with fusion protein. (Original magnification: ×200)
-
-
其他:
產品詳情
-
Uniprot No.:
-
基因名:
-
別名:CANDF2 antibody; CARD9 antibody; CARD9_HUMAN antibody; Caspase recruitment domain family member 9 antibody; Caspase recruitment domain-containing protein 9 antibody; hCARD9 antibody
-
宿主:Rabbit
-
反應種屬:Human
-
免疫原:Fusion protein of Human CARD9
-
免疫原種屬:Homo sapiens (Human)
-
標記方式:Non-conjugated
-
抗體亞型:IgG
-
純化方式:Antigen affinity purification
-
濃度:It differs from different batches. Please contact us to confirm it.
-
保存緩沖液:-20°C, pH7.4 PBS, 0.05% NaN3, 40% Glycerol
-
產品提供形式:Liquid
-
應用范圍:ELISA,IHC
-
推薦稀釋比:
Application Recommended Dilution ELISA 1:2000-1:10000 IHC 1:100-1:300 -
Protocols:
-
儲存條件:Upon receipt, store at -20°C or -80°C. Avoid repeated freeze.
-
貨期:Basically, we can dispatch the products out in 1-3 working days after receiving your orders. Delivery time maybe differs from different purchasing way or location, please kindly consult your local distributors for specific delivery time.
-
用途:For Research Use Only. Not for use in diagnostic or therapeutic procedures.
相關產品
靶點詳情
-
功能:Adapter protein that plays a key role in innate immune response against fungi by forming signaling complexes downstream of C-type lectin receptors. CARD9-mediated signals are essential for antifungal immunity against a subset of fungi from the phylum Ascomycota. Transduces signals in myeloid cells downstream of C-type lectin receptors CLEC7A (dectin-1), CLEC6A (dectin-2) and CLEC4E (Mincle), which detect pathogen-associated molecular pattern metabolites (PAMPs), such as fungal carbohydrates, and trigger CARD9 activation. Upon activation, CARD9 homooligomerizes to form a nucleating helical template that recruits BCL10 via CARD-CARD interaction, thereby promoting polymerization of BCL10 and subsequent recruitment of MALT1: this leads to activation of NF-kappa-B and MAP kinase p38 (MAPK11, MAPK12, MAPK13 and/or MAPK14) pathways which stimulate expression of genes encoding pro-inflammatory cytokines and chemokines. CARD9 signaling in antigen-presenting cells links innate sensing of fungi to the activation of adaptive immunity and provides a cytokine milieu that induces the development and subsequent of interleukin 17-producing T helper (Th17) cells. Also involved in activation of myeloid cells via classical ITAM-associated receptors and TLR: required for TLR-mediated activation of MAPK, while it is not required for TLR-induced activation of NF-kappa-B. CARD9 can also be engaged independently of BCL10: forms a complex with RASGRF1 downstream of C-type lectin receptors, which recruits and activates HRAS, leading to ERK activation and the production of cytokines. Acts as an important regulator of the intestinal commensal fungi (mycobiota) component of the gut microbiota. Plays an essential role in antifungal immunity against dissemination of gut fungi: acts by promoting induction of antifungal IgG antibodies response in CX3CR1(+) macrophages to confer protection against disseminated C.albicans or C.auris infection. Also mediates immunity against other pathogens, such as certain bacteria, viruses and parasites; CARD9 signaling is however redundant with other innate immune responses. In response to L.monocytogenes infection, required for the production of inflammatory cytokines activated by intracellular peptidoglycan: acts by connecting NOD2 recognition of peptidoglycan to downstream activation of MAP kinases (MAPK) without activating NF-kappa-B.
-
基因功能參考文獻:
- CARD9 deficiency can present with a phenotype of spontaneous candidal endophthalmitis. We report 2 novel mutations in CARD9, both affecting splicing, expanding the range of morbid variants causing CARD9 deficiency, emphasising the importance of both genomic and cDNA sequencing for this condition. PMID: 28984994
- Our results reveal a molecular mechanism for CLR-mediated Card9 regulation that controls innate immunity to fungal infections PMID: 27926862
- The IBD risk allele at CARD9 rs10781499 is associated with reduced aryl hydrocarbon activation by microbiota-derived metabolites extracted from fecal samples of IBD patients. PMID: 27158904
- Card9 in severe acute pancreatitis patients was overexpressed, suggesting the close correlation with the outcome and severity of pancreatic injury in patients. PMID: 26893103
- CARD9 allele C (p = 0.012) and genotype CC (p = 0.012) were significant protective factors against ankylosing spondylitis only in HLA-B27-negative patients. PMID: 26590821
- The findings linked, for the first time, mutations leading to CARD9 deficiencies with susceptibility to opportunistic filamentous fungi. PMID: 26440558
- Chronic and invasive fungal infections have been described in a Turkish consanguineous family with CARD9 deficiency. PMID: 26961233
- We observed no significant association between the investigated CARD9 SNPs and the susceptibility of either Crohn's disease or ulcerative colitis PMID: 26722558
- This study identified two novel independent loci (MAP3K14 and CARD9) strongly associated with joint damage in Mexican Americans and European Americans and a few shared loci showing suggestive evidence for association. PMID: 26498133
- Impaired RASGRF1/ERK-mediated GM-CSF response characterizes CARD9 deficiency in French-Canadians. PMID: 26521038
- homozygous mutation results in deep dermatophytosis due to impaired neutrophil fungal killing PMID: 26044242
- our data highlight the critical role of CARD9-dependent neutrophil trafficking into the central nervous system PMID: 26679537
- A CARD9 variant (protective against inflammatory bowel disease)is C-terminally truncated and acts in a dominant-negative manner for CARD9-mediated cytokine production. K125 is the CARD9 ubiquitinated residue. Ubiquitination is needed for CARD9 activity. PMID: 26488816
- These results indicate that CARD9 is indispensable for Phialophora verrucosa killing by polymorphonuclear neutrophils. PMID: 25790941
- Data indicate that MINCLE receptor is able to mediate the response to trehalose-6,6-dimycolate (TDM) dependent on SYK kinase and CARD9 protein. PMID: 26202982
- MyD88 and CARD9 act in two discrete phases and in two cellular compartments to direct chemokine- and neutrophil-dependent host defense. PMID: 25621893
- In a patient with CARD9 deficiency, clinical remission with adjunctive GM-CSF therapy suggested that a CARD9/GM-CSF axis contributes to susceptibility to candidiasis. PMID: 24704721
- Invasive infections of the CNS or digestive tract caused by Candida species in previously healthy children and adults might be caused by inherited CARD9 deficiency. PMID: 25702837
- These are the first 2 patients with inherited CARD9 deficiency. PMID: 25057046
- Results indicating that CARD9 is a regulator of metastasis-associated macrophages will lead to new insights into evolution of the microenvironments supporting tumor metastasis. PMID: 24722209
- CARD9 regulates H-Ras activation by linking Ras-GRF1 to H-Ras, which mediates Dectin-1-induced extracellular signal-regulated protein kinase (ERK) activation and proinflammatory responses when stimulated by their ligands. PMID: 25267792
- There is emergening evidence that genetic component is inviolved in the development of onychomycosis.(review) PMID: 24686315
- A new genome-wide significant association between CARD9 and IgA nephropathy. PMID: 25305756
- Intestinal failure patients with CARD9 polymorphism are less likely to develop progressive liver disease. PMID: 24465786
- Our study confirmed that an SNP rs11145835 in 9q34.3 that harbors CARD9 and SNAPC4 is associated with ankylosing spondylitis in a Chinese Han population PMID: 24334645
- this study reports a direct cytosolic interaction between the DNA-damage sensor Rad50 and the innate immune system adaptor CARD9. PMID: 24777530
- CARD9 mutations linked to subcutaneous phaeohyphomycosis and TH17 cell deficiencies. PMID: 24231284
- CARD9 may be involved in hepatic carcinogenesis associated with hepatitis C in Egyptian patients. PMID: 24018495
- All the patients with deep dermatophytosis had autosomal recessive CARD9 deficiency. PMID: 24131138
- Rubicon as a specific feedback inhibitor of CARD9-mediated pattern recognition receptor-signal transduction, preventing unbalanced proinflammatory responses. PMID: 22423967
- Human coronavirus-induced neuronal programmed cell death required cyclophilin d but not caspase 3 caspase 9 activities. PMID: 22013052
- variation in CARD9 genes was not associated with susceptibility to opportunistic fungal or bacterial infections in HIV-positive patients. PMID: 21985303
- genetic variation in CARD9 was not associated with susceptibility to candidemia. PMID: 21881131
- Three ulcerative colitis susceptibility loci are associated with primary sclerosing cholangitis and indicate a role for IL2, REL, and CARD9. PMID: 21425313
- High caspase-9 activity is associated with cervical malignancy. PMID: 21436691
- The single nucleotide polymorphisms most strongly associated with ankylosing spondylitis are those most associated with CARD9 expression. PMID: 20463747
- Studies suggest that the apoptosome contains a 1:1 Apaf-1:caspase-9 stoichiometry. PMID: 19809088
- Data show that pVHL acts as an adaptor to promote the inhibitory phosphorylation of the NF-kappaB agonist Card9 by casein kinase 2. PMID: 17936701
- CARD9 and IL18RAP are IBD loci important in innate immunity in the predisposition to both CD and UC. PMID: 18439550
- An autosomal recessive form of susceptibility to chronic mucocutaneous candidiasis is associated with homozygous mutations in CARD9. PMID: 19864672
顯示更多
收起更多
-
相關疾病:Candidiasis, familial, 2 (CANDF2)
-
亞細胞定位:Cytoplasm.
-
組織特異性:Expression is restricted to several populations of phagocytes, such as macrophages, monocytes, and dendritic cells. Highly expressed in spleen. Also detected in liver, placenta, lung, peripheral blood leukocytes and in brain.
-
數據庫鏈接:
Most popular with customers
-
-
Phospho-YAP1 (S127) Recombinant Monoclonal Antibody
Applications: ELISA, WB, IHC
Species Reactivity: Human
-
-
-
-
-
-